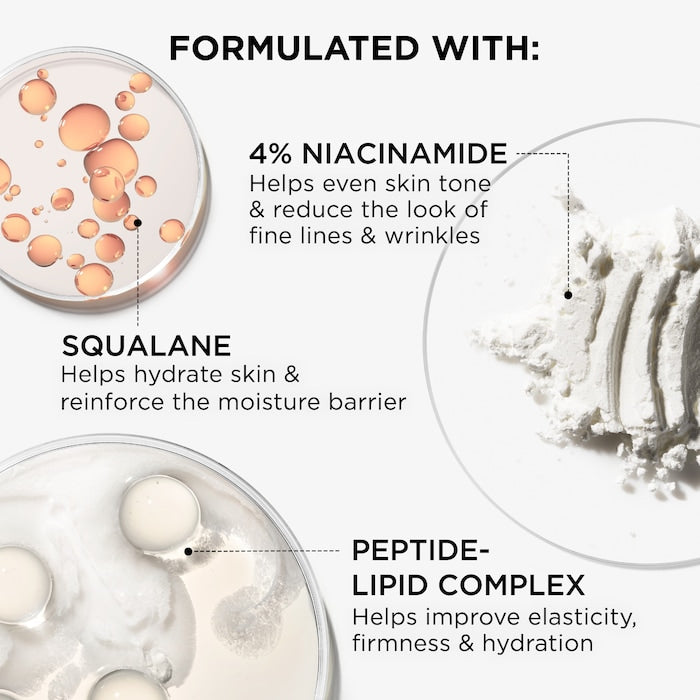

Couldn't load pickup availability
IT Cosmetics Confidence in a Cream is a luxurious, multi-benefit anti-aging moisturizer that deeply hydrates while visibly smoothing and firming the skin. Powered by niacinamide, squalane, ceramides, and a peptide-lipid complex, this original it cosmetics confidence in a cream gives a youthful, radiant complexion and is available at Heavenly Cosmetics in Egypt.
Intense Hydration – Provides up to 48 hours of deep hydration, leaving the skin nourished and plump.
Anti-Aging Benefits – Reduces the appearance of fine lines and wrinkles, smoothing and firming mature skin.
Restores Skin Barrier – Strengthens and helps protect the skin barrier with ceramides and squalane.
Evens Tone and Texture – Niacinamide helps even out skin tone and texture for a smoother complexion.
Non-Comedogenic – Suitable for all skin types, including sensitive and acne-prone skin.
Available Size:
7 ml (Mini / Travel size)
Dermatologist-Tested – Safe and effective for all skin types.
Non-Greasy Formula – Quickly absorbs without leaving a heavy or greasy residue.
Suitable for Sensitive Skin – Gentle enough for daily use on sensitive skin.
Supports Mature Skin – Ideal for mature skin, offering visible anti-aging results.
Vegan Formula – Free from animal-derived ingredients.

After cleansing and applying any serums, take a small amount of cream.
Warm it between your fingers and gently massage it onto your face and neck using upward motions.
Use both morning and night for best results. Follow with sunscreen during the day.
Is Confidence in a Cream good for mature skin?
Yes, it’s specifically formulated to target the visible signs of aging, including fine lines and wrinkles, making it perfect for mature skin.
How do I use IT Cosmetics Confidence in a Cream?
Apply it after cleansing and serums, massaging it gently onto the face and neck. Use both morning and night.
What is in IT Cosmetics Confidence in a Cream?
It contains a blend of potent ingredients including niacinamide, squalane, ceramides, and a peptide-lipid complex that work together to hydrate, firm, and restore your skin.
Please note we don’t offer returns and we always make sure to get your products delivered safe and sound, from our haven to yours! However, if the item you receive is damaged/doesn’t match what you have previously ordered, then we would love the chance to make it right. Eligible items must be received unused, unopened, and undamaged within less than 1 day from the day you received your order. Returns that do not meet our policy will be sent back to you without a refund.
We understand if you change your mind (impulsive buying is a thing). This could play out in different ways:
Thanks for subscribing!
This email has been registered!